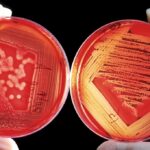

Papež František přirovnal EU k „nacistické diktatuře“, protože se snaží zavést pravidla pro jazyk a zakázat používání slova Vánoce. (Foto: Shutterstock)Čtyřiaosmdesátiletý papež varoval blok, aby se „nevydával cestou ideologické kolonizace“, když se po čtyřdenní cestě vrátil z Řecka.Minulý týden byla EU obviněna ze snahy „zrušit Vánoce“ poté, co zaměstnancům nařídila, aby se tomuto slovu vyhýbali …
Papež přirovnal EU k „nacistické diktatuře“, po možném zákazu slova Vánoce

Papež František přirovnal EU k „nacistické diktatuře“, protože se snaží zavést pravidla pro jazyk a zakázat používání slova Vánoce. (Foto: Shutterstock)
Čtyřiaosmdesátiletý papež varoval blok, aby se „nevydával cestou ideologické kolonizace“, když se po čtyřdenní cestě vrátil z Řecka.
Minulý týden byla EU obviněna ze snahy „zrušit Vánoce“ poté, co zaměstnancům nařídila, aby se tomuto slovu vyhýbali ve prospěch „svátečního období“, protože by mohlo být urážlivé pro nekřesťany.
Eurokraté toto pravidlo zveřejnili před několika měsíci jako součást příručky o „inkluzivní komunikaci“, jejíž podrobnosti unikly na veřejnost, což vedlo k zuřivé reakci.
Mezi další návrhy v knize patřilo nahrazení křesťanských jmen, jako jsou Marie a Jan, „mezinárodními“ jmény, jako jsou Malika a Julio, pokud se používají v obecných příkladech, a nahrazení slova „vytvořený člověkem“ slovem „způsobený člověkem“.
Na palubě papežského letadla při návratu do Vatikánu řekl: „Je to něco, co v historii nefungovalo. V historii se o to pokoušelo mnoho diktatur. Mám na mysli Napoleona, nacistickou diktaturu, komunistickou diktaturu‘.“
Dodal, že EU je „nezbytná“, ale musí se vyvarovat rozdmýchávání rozporů mezi svými členskými státy.
Řekl: „Evropská unie… musí být opatrná, aby se nevydala cestou ideologické kolonizace. To by mohlo vést k rozdělení zemí a ke krachu EU.“
Zdroj: dailymail.co.uk
Odebírejte náš newsletter
Zůstaňte v kontaktu s novinkami